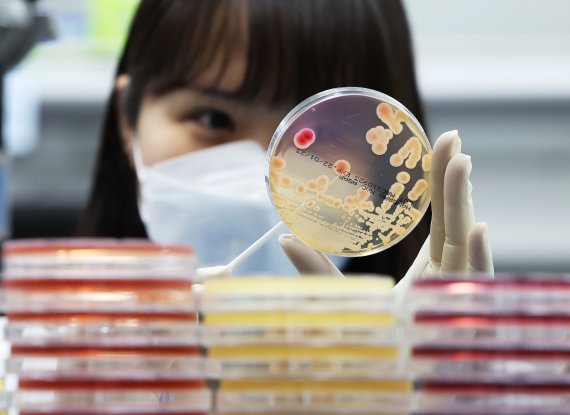
폭염과 장마 등으로 식중독 위험이 증가하고 있는 19일 경기도 수원시 권선구 경기도보건환경연구원에서 연구원들이 식중독균 배양분리작업 시연을 하고 있다. /연합뉴스

[파이낸셜뉴스] 이른 무더위와 사회적 거리두기 완화로 인한 외부활동이 증가하면서 식중독 환자수가 작년보다 2배 이상 급증한 것으로 나타났다. 특히 어린이집, 학교 등 집단급식소에서 식중독 발생자가 가장 많았다.
19일 식품의약품안전처에에 따르면 올해 6월 식중독 신고는 53건 1198명으로 지난해 6월 44건, 585명 보다 훌쩍 높아진 것으로 집계됐다. 신고 의심환자수만 보면 전년보다 두배 이상 많아진 것이다. 올 상반기로 보면 식중독 의심신고 발생은 오히려 예년에 비해 낮았으나 6월부터 식중독 발생이 늘어난 점이 특징이다.
이른 폭염에…6월에만 53건 1198명 신고
식약처는 그 원인으로 여름철 이른 고온현상을 꼽았다. 최근 연평균 기온이 지속적으로 상승 중인데, 지난 2002년 연평균 12.4도였던 기온이 2020년 13.3도로 높아지며 지난 20년간 약 0.9도 상승했다. 한국보건사회연구원에 따르면 평균기온 1도 상승 시 식중독 건수는 5.3%, 환자수는 6.2% 증가한다.
특히 겨울철에 주로 발생하는 노로바이러스 감염이 어린이집, 유치원 등 영유아 보육시설에서 7월까지 지속적으로 유행한 점도 영향을 미쳤다는 분석이다. 아울러 거리두기 해제로 지역 축제가 활성화된 영향도 꼽혔다. 음식점의 이용 빈도가 증가하고 야외활동과 축제 개최가 증가하면서 식중독 의심 신고도 늘어났다는 것이다. 지난달 대거 식중독 의심환자가 발생한 기장군 어르신 축제와 성주군 식당에서의 집단감염이 대표적인 사례다.
또 여름이 되면 계절식품인 냉면과 밀면 등의 소비가 증가하는데, 해당 식품들은 고온다습한 환경에서 조리되기 때문에 위생문제가 발생할 우려가 높은 식품들이다.
식약처 "집단급식소·음식점 위생점검 강화"
1인가구 증가에 따른 배달시장 증대와 함께 김밥과 햄버거 등 즉석섭취식품 소비층이 지속적으로 증가한 점도 식중독 발생 빈도를 높인 원인으로 꼽힌다. 무엇보다 코로나19로 인해 현장점검 건수가 줄어든 것도 원인으로 지적됐다. 지자체 위생담당공무원들이 코로나시기에 대부분 방역활동에 집중하며, 위생점검이 줄어들었다는 것이다.
한편 6월 식중독 발생 중 최다 신고 장소는 어린이집, 학교 등 집단급식소(26건, 487명)로 집계됐다. 그뒤를 이어 음식점(20건 353명), 지역행사 등 기타장소(7건 358명) 순으로 조사됐다. 식약처는 "코로나19 재유행 위험과 함께 식중독이 늘면서 식품안전관리에 대한 국민들의 우려가 증대하고 있다"면서 "발생건수가 많은 집단급식소나 위생취약 음식점의 위생점검을 강화할 것"이라고 밝혔다.
aber@fnnews.com 박지영 기자
※ 저작권자 ⓒ 파이낸셜뉴스, 무단전재-재배포 금지